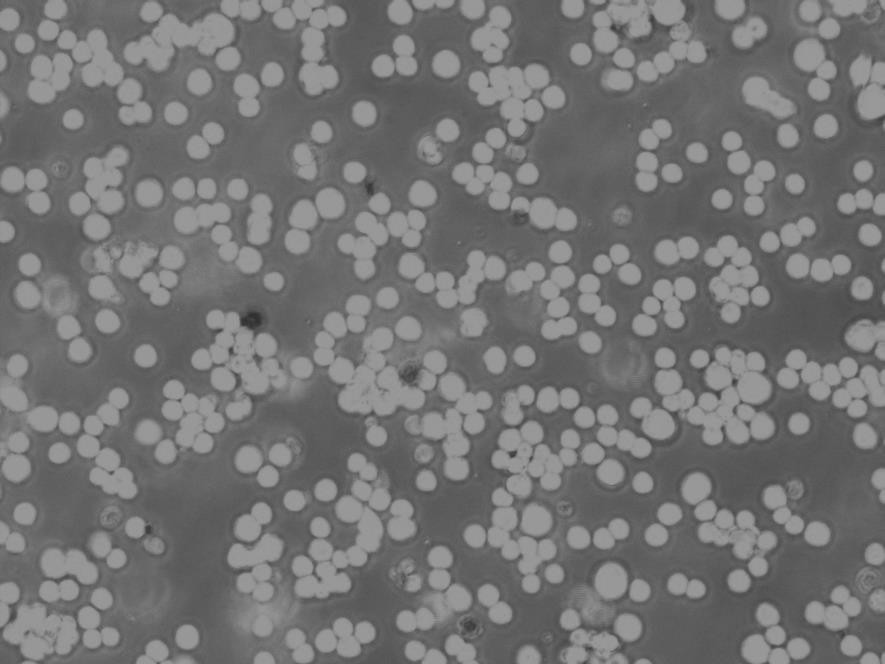
UMNSAH/DF-1 Cells鸡胚成纤维贴壁细胞系(提供所有细胞STR鉴定图谱)

"UMNSAH/DF-1 Cells鸡胚成纤维贴壁细胞系(提供所有细胞STR鉴定图谱)
传代比例:1:2-1:4(首次传代建议1:2)
背景信息:详见相关文献介绍
┈订┈购(技术服务)┈热┈线:1┈3┈6┈4┈1┈9┈3┈0┈7┈9┈1【微信同号】┈Q┈Q:3┈1┈8┈0┈8┈0┈7┈3┈2┈4;
hTERT-HME1 Cells;背景说明:详见相关文献介绍;传代方法:1:2-1:3传代;每周换液2-3次。;生长特性:贴壁或悬浮,详见产品说明书部分;形态特性:详见产品说明书;相关产品有:A-673细胞、COLO 320 HSR细胞、NL-20细胞
Panc_03_27 Cells;背景说明:详见相关文献介绍;传代方法:1:2传代;生长特性:贴壁生长;形态特性:上皮样;相关产品有:A2780/Taxol细胞、Strain KB细胞、GP293细胞
T-T Cells;背景说明:详见相关文献介绍;传代方法:10^5 cells/60mm dish;生长特性:贴壁生长;形态特性:上皮细胞样;相关产品有:CWR22-Rv1细胞、32D clone3细胞、SBC-5细胞
HCC1569 Cells;背景说明:详见相关文献介绍;传代方法:1:4—1:6传代,每周换液2—3次;生长特性:混合生长;形态特性:上皮样;相关产品有:MC57细胞、UPCI-SCC-154细胞、SU86-86细胞
换液周期:每周2-3次
培养细胞真的不难,Zui关键几点:1)所有的东西使用,如果你用的血清、培养皿、培养基、胰酶什么的都是进口的,真的很难相信你会把细胞养坏;2)动作要快,胰酶消化,换什么,细胞暴露在空气中的时间越少越HAO。另外,要掌握HAO胰酶消化时间,所谓的细胞状态差,很多时候是传代的原因;3)有时间的话,需要细胞计数,传相应数目的细胞到培养皿中,可以大致清楚细胞的生长曲线,不会临时要处理,手足无措;4)要做什么心里要非常清楚,合理安排时间,传代细胞的实验穿插进行,可以节省很多时间,也不会耽误别人的实验;5)个人的实验器具自己收一套,不要和别人混用,Zui近换了什么新的东西稍微记一下,试剂一旦怀疑污染,马上丢;6)传代细胞不能进去太多人,避免相互干扰。每天对待细胞比孝敬爹妈还用心,那真是捧在手里怕碎了,含在嘴里怕化了,看在眼里怕丢了,培养细胞时有哪些经验教训可以分享呢?1)严格无菌操作,多喷喷酒精,要是对灭菌的东西不放心,自己包自己送自己烘干;2)不要和别人共用试剂耗材,自己准备一套;3)有可能的话在拿到新细胞的时候做HAO支原体衣原体检测;4)水浴锅很脏,生化培养箱要是得手动加湿的话盘里的水也会很脏,勤换(灭菌水加进去);5)晚上离开的时候ZuiHAO给传代细胞照紫外,超净台是用完就开;6)是同一时间就你一个人在用传代细胞在养细胞。
UMNSAH/DF-1 Cells鸡胚成纤维贴壁细胞系(提供所有细胞STR鉴定图谱)
生长特性:贴壁生长
产品包装:复苏发货:T25培养瓶(一瓶)或冻存发货:1ml冻存管(两支)
H676B Cells;背景说明:详见相关文献介绍;传代方法:1:2-1:3传代;每周换液2-3次。;生长特性:贴壁或悬浮,详见产品说明书部分;形态特性:详见产品说明书;相关产品有:CEM T4细胞、AN3细胞、ROS1728细胞
CCD-841-CoN Cells;背景说明:结肠上皮细胞;女性;传代方法:1:2-1:3传代;每周换液2-3次。;生长特性:贴壁;形态特性:详见产品说明书;相关产品有:DOK细胞、SK MEL 28细胞、LK 2细胞
H-889 Cells;背景说明:详见相关文献介绍;传代方法:每周换液2-3次;生长特性:贴壁或悬浮,详见产品说明书部分;形态特性:上皮细胞;相关产品有:NCI-H1930细胞、NS-I/1细胞、SCL-1细胞
MC-38 Cells;背景说明:详见相关文献介绍;传代方法:1:2传代;生长特性:贴壁生长;形态特性:上皮细胞样;相关产品有:OE-21细胞、SUDHL8细胞、HeLa S3细胞
┈订┈购(技术服务)┈热┈线:1┈3┈6┈4┈1┈9┈3┈0┈7┈9┈1【微信同号】┈Q┈Q:3┈1┈8┈0┈8┈0┈7┈3┈2┈4;
来源说明:细胞主要来源ATCC、ECACC、DSMZ、RIKEN等细胞库
细胞接收操作说明:请仔细阅读本操作说明及相应的细胞说明书。本公司细胞发货有四种形式:25培养瓶(一般是贴壁细胞使用,悬浮细胞也可以)、离心管(悬浮细胞使用多,当然,有些公司也会用这种离心管形式发贴壁细胞,但是,长期经验来说,贴壁细胞容易发生形态变化,估计是细胞培养空间狭小,血清不足导致(Zui主要是怕运输延误导致这些情况发生),个人不建议用离心管形式发贴壁细胞)及干冰(冻存细胞用,主要是冬天天气冷,温度低于4℃的地方,都要考虑冻存细胞)。25培养瓶:是用25细胞培养瓶直接发货的形式。收到细胞后,拆开包装25培养瓶的自封袋,不拆封口膜,表面喷75%酒精消毒后显微镜观察细胞状态(有条件可以拍下此时细胞照片)。将细胞放入37度培养箱平衡两小时以上,再处理细胞。首先将25中培养基取出装HAO备用,如细胞密度GAO于80%,可以直接消化传代,相反则加入5-6ml培养基放回培养箱继续培养即可。离心管:是用15ml离心管发货的形式,只用于悬浮细胞发货。收到细胞后消毒处理及将细胞放入37度培养箱平衡两小时以上,再处理细胞。首先将25中培养基取出装HAO备用(如果实验室没有25培养瓶,可以暂时75培养瓶,加入10-15ml培养基,建议10ml培养基,也可以使用175培养瓶,加入50-60ml培养基,培养瓶越大,需要的培养基越多。当然如果刚接收到细胞密度不够的话,ZuiHAO不用大瓶子,先用小瓶子养起来再换大的,不然会长得很慢,严重的,会导致细胞死亡等危险),平衡完成后,离心(1000rpm,3min)收集细胞,弃上清,用新的培养基重悬细胞并接种至培养瓶或皿中,放回培养箱继续培养。干冰:是用本公司冻存冻存细胞后,直接用干冰将冻存的细胞冷冻发货的形式。收到细胞后按照细胞复苏的步骤操作即可。
物种来源:人源、鼠源等其它物种来源
UMNSAH/DF-1 Cells鸡胚成纤维贴壁细胞系(提供所有细胞STR鉴定图谱)
形态特性:上皮细胞样
上皮细胞(epithelial cell)是构成上皮组织的基本单位,广泛分布在人体的各个表面和体腔内,外胚层来源:皮肤、腺垂体、内耳膜、角膜、晶状体、鼻腔、口腔、肛门等处的上皮细胞由外胚层发育而来。中胚层来源:间皮、内皮等上皮细胞由中胚层发育而来。内胚层来源:中耳、呼吸道、肺、胸腺、消化道、消化腺、膀胱、阴道、甲状腺、甲状旁腺等处的上皮细胞由内胚层发育而来。许多癌症起源于上皮细胞,如肝细胞癌、结直肠癌、乳腺癌、肺癌、胃癌、前列腺癌、卵巢癌和子宫内膜癌。这些癌症中的上皮细胞通常表现出细胞标志物的变化,如E-cadherin的缺失和N-cadherin、vimentin等间充质细胞标志物的表达上调。
430F Cells(提供STR鉴定图谱)
Abcam Jurkat PEF1 KO Cells(提供STR鉴定图谱)
ALZ.38 Cells(提供STR鉴定图谱)
BayGenomics ES cell line RRK097 Cells(提供STR鉴定图谱)
BayGenomics ES cell line XL067 Cells(提供STR鉴定图谱)
CaES-17 Cells(提供STR鉴定图谱)
DA00500 Cells(提供STR鉴定图谱)
DA06009 Cells(提供STR鉴定图谱)
GM00442 Cells(提供STR鉴定图谱)
MM1-S Cells;背景说明:详见相关文献介绍;传代方法:1:2-1:4传代,2-3天换液1次。;生长特性:混合生长;形态特性:淋巴母细胞样;相关产品有:NR8383细胞、L-M (TK-)细胞、UMRC2细胞
H-865 Cells;背景说明:详见相关文献介绍;传代方法:1:2-1:3传代;每周换液2-3次。;生长特性:贴壁或悬浮,详见产品说明书部分;形态特性:详见产品说明书;相关产品有:Huh-7.5细胞、A20细胞、SKES-1细胞
GM03320D Cells;背景说明:该细胞是1967年4月由NicholsWW,LeeJ和DwightS建立,来源于一名13月龄白人男婴腹部肿块,临床诊断为神经母细胞瘤,伴有极少部位的类器官样分化。;传代方法:1:2传代;生长特性:贴壁生长;形态特性:存在两种细胞类型,小的神经母细胞样细胞和大的透明成纤维样细胞;相关产品有:TK.10细胞、HLEB3细胞、RH35细胞
BT483 Cells;背景说明:详见相关文献介绍;传代方法:1:2传代,2—3天换液一次;生长特性:贴壁生长;形态特性:上皮细胞样;相关产品有:SN-12C细胞、RPMI8226/S细胞、NCI-H1648细胞
Tca-8113 Cells;背景说明:舌鳞癌;女性;传代方法:1:2-1:3传代;每周换液2-3次。;生长特性:贴壁;形态特性:详见产品说明书;相关产品有:KM12细胞、Hca-F细胞、NP-69细胞
XWLC-05 Cells;背景说明:肺癌;女性;传代方法:1:2-1:3传代;每周换液2-3次。;生长特性:贴壁;形态特性:详见产品说明书;相关产品有:H1770细胞、V79-1细胞、Hela-mock细胞
MCF-7/ADR-RES Cells;背景说明:详见相关文献介绍;传代方法:1:2-1:3传代;每周换液2-3次。;生长特性:贴壁或悬浮,详见产品说明书部分;形态特性:详见产品说明书;相关产品有:PT67细胞、B16-F0细胞、MDAMB-231细胞
SNUC2B Cells;背景说明:详见相关文献介绍;传代方法:1:2-1:3传代;每周换液2-3次。;生长特性:贴壁或悬浮,详见产品说明书部分;形态特性:详见产品说明书;相关产品有:PaTu 8988 S细胞、H-727细胞、C-28/I2细胞
SKCol1 Cells;背景说明:该细胞来源于结直肠病人的转移性腹水。;传代方法:1:2-1:3传代,每周2-3次。;生长特性:贴壁生长;形态特性:上皮细胞样;相关产品有:AtT 20细胞、NCIH250细胞、OVCAR-8/ADR细胞
Caco-2BBe Cells;背景说明:详见相关文献介绍;传代方法:1:6—1:10传代,每周换液2次;生长特性:贴壁生长;形态特性:上皮细胞;相关产品有:SW 954细胞、SCC-9细胞、NCI-H2141细胞
Walker/LLC-WRC 256 Cells;背景说明:乳腺癌;雌性;传代方法:1:2-1:3传代;每周换液2-3次。;生长特性:贴壁;形态特性:详见产品说明书;相关产品有:GM05384细胞、Panc8.13细胞、HCT 8细胞
MCF-12A Cells;背景说明:非致瘤性乳腺上皮细胞;女性;传代方法:1:2-1:3传代;每周换液2-3次。;生长特性:贴壁;形态特性:详见产品说明书;相关产品有:LSC-1细胞、SKHEP-1细胞、EB-2细胞
P3-X63Ag8.653 Cells;背景说明:详见相关文献介绍;传代方法:1:2-1:3传代;每周换液2-3次。;生长特性:贴壁或悬浮,详见产品说明书部分;形态特性:详见产品说明书;相关产品有:PL-11细胞、RMS1598细胞、MUTZ-1细胞
VE Cells;背景说明:血管;内皮 Cells;传代方法:1:2-1:3传代;每周换液2-3次。;生长特性:贴壁;形态特性:详见产品说明书;相关产品有:GC-2spd(ts)细胞、LM3细胞、EA.Hy926细胞
COLO-699 Cells;背景说明:详见相关文献介绍;传代方法:1:2-1:3传代;每周换液2-3次。;生长特性:贴壁或悬浮,详见产品说明书部分;形态特性:详见产品说明书;相关产品有:LI7细胞、CMT-64细胞、BSC-1细胞
HEK 293 Cells;背景说明:详见相关文献介绍;传代方法:1:2-1:3传代;每周换液2-3次。;生长特性:贴壁或悬浮,详见产品说明书部分;形态特性:详见产品说明书;相关产品有:WM266细胞、PaTu8988s细胞、LN382细胞
HEK 293 Cells;背景说明:详见相关文献介绍;传代方法:1:2-1:3传代;每周换液2-3次。;生长特性:贴壁或悬浮,详见产品说明书部分;形态特性:详见产品说明书;相关产品有:WM266细胞、PaTu8988s细胞、LN382细胞
UMNSAH/DF-1 Cells鸡胚成纤维贴壁细胞系(提供所有细胞STR鉴定图谱)
SK-ES Cells;背景说明:详见相关文献介绍;传代方法:1:2-1:5传代;每周换液2-3次;生长特性:贴壁或悬浮,详见产品说明书部分;形态特性:上皮样;相关产品有:LK 2细胞、Emory University-3细胞、U-138 MG细胞
SNU-368 Cells;背景说明:详见相关文献介绍;传代方法:1:2传代;生长特性:贴壁生长;形态特性:上皮细胞样;相关产品有:AML12细胞、MS 751细胞、5-8F细胞
HEK 293-H Cells;背景说明:详见相关文献介绍;传代方法:1:2-1:3传代;每周换液2-3次。;生长特性:贴壁或悬浮,详见产品说明书部分;形态特性:详见产品说明书;相关产品有:Hs870T细胞、KYSE510细胞、PLA801-95C细胞
RC-4B Cells;背景说明:详见相关文献介绍;传代方法:1:2-1:3传代;每周换液2-3次。;生长特性:贴壁或悬浮,详见产品说明书部分;形态特性:详见产品说明书;相关产品有:RIN-14B细胞、MDA468细胞、MonoMac1细胞
3T3-A31 Cells;背景说明:胚胎;成纤维;自发永生;雄性;BALB/c;传代方法:1:2-1:3传代;每周换液2-3次。;生长特性:贴壁;形态特性:详见产品说明书;相关产品有:RBE细胞、Sun Yat-sen university Ophtalmic center-Retinoblastoma 50细胞、SupB15WT细胞
NCIH1930 Cells;背景说明:详见相关文献介绍;传代方法:3-4天换液1次。;生长特性:悬浮生长;形态特性:详见产品说明书;相关产品有:Hs888Lu细胞、LLC1细胞、NCI-H676细胞
┈订┈购(技术服务)┈热┈线:1┈3┈6┈4┈1┈9┈3┈0┈7┈9┈1【微信同号】┈Q┈Q:3┈1┈8┈0┈8┈0┈7┈3┈2┈4;
SK-N-BE(2C) Cells;背景说明:神经母细胞瘤;骨髓转移;男性;传代方法:1:2-1:3传代;每周换液2-3次。;生长特性:贴壁;形态特性:详见产品说明书;相关产品有:MOLP8细胞、INS1E细胞、LM2-4175细胞
1E8-H Cells;背景说明:前列腺癌;男性;传代方法:1:2-1:3传代;每周换液2-3次。;生长特性:贴壁;形态特性:详见产品说明书;相关产品有:RPMI 7666细胞、RBSMC细胞、LNCaP细胞
CHG5 Cells;背景说明:少突神经胶质瘤;男性;传代方法:1:2-1:3传代;每周换液2-3次。;生长特性:贴壁;形态特性:详见产品说明书;相关产品有:BE2-M17细胞、OCI-Ly1细胞、UCLA-SO-M20细胞
MEG-01 Cells;背景说明:MEG-01细胞株源自一位CML患者成巨核细胞转换期的骨髓细胞。细胞质因子VIII和表面球蛋白IIb/IIIa,-Schiff(PAS)反应,α醋酸酯酶和酸性酶阳性。髓过氧化物酶,α酯酶,化醋酸AS-D酯酶和碱性酶阴性。用单克隆抗体BA-1(抗B细胞,粒性白细胞),HPL-3(抗球蛋白IIb/IIIa)和20.3(抗单核细胞,血小板)染色成阳性。其他淋巴和骨髓类抗体成阴性。;传代方法:1:2传代。3天内可长满。;生长特性:悬浮生长;形态特性:淋巴母细胞样;相关产品有:NCI-H165细胞、CAL 33细胞、LOU-NH91细胞
H87 Cells;背景说明:NCI-N87细胞表达表面糖蛋白癌胚抗原(CEA)和TAG72,并且没有左旋多巴胺脱羧酶(DDC)活性。它们的血管活性的肠肽(VIP)受体活性极低并缺乏胃泌激素受体。它们表达蕈毒碱胆碱受体。没有证据表明存在N-myc,L-myc,myb和EGF受体基因的重组。这个细胞株表达的c-myc和c-erb-B2RNA水平与其它细胞株相当。以下基因不表达:N-myc,L-myc,c-cis,IGF-2,或胃泌激素释放肽。报道NCI-N87细胞的植板率为4.3%。;传代方法:消化15-20分钟。1:2。4-5天长满。;生长特性:贴壁生长;形态特性:上皮细胞样;相关产品有:LNCaP-ATCC细胞、HEK293F细胞、RC-2细胞
SPDC-CCL141 Cells;背景说明:详见相关文献介绍;传代方法:1:2传代;生长特性:贴壁生长;形态特性:成纤维母细胞样;相关产品有:CCC-HEH-2细胞、CHP-126细胞、LTEP a2细胞
GM12702 Cells(提供STR鉴定图谱)
HAP1 EZR (-) 1 Cells(提供STR鉴定图谱)
HAP1 XKR8 (-) 1 Cells(提供STR鉴定图谱)
HIVE-79/7-2 Cells(提供STR鉴定图谱)
iPS-SCU-CD34+ #2 Cells(提供STR鉴定图谱)
MC-MA1 Cells(提供STR鉴定图谱)
ND11211 Cells(提供STR鉴定图谱)
PLHC-1 Cells(提供STR鉴定图谱)
SH-SY5YrDOX20 Cells(提供STR鉴定图谱)
Ubigene A-549 CACNA1G KO Cells(提供STR鉴定图谱)
UoC-B8 Cells(提供STR鉴定图谱)
2B2 [Mouse hybridoma against human GOLM1] Cells(提供STR鉴定图谱)
H-28 Cells;背景说明:详见相关文献介绍;传代方法:1:3-1:6传代,每周换液2-3次;生长特性:贴壁生长;形态特性:详见产品说明书;相关产品有:NCIH2126细胞、NCI-H2228细胞、UACC-812细胞
C32-mel Cells;背景说明:详见相关文献介绍;传代方法:1:2-1:4传代,2天换液1次。;生长特性:贴壁生长;形态特性:详见产品说明书;相关产品有:GLAG-66细胞、huH 1细胞、WEHI-279细胞
UT-7 Cells;背景说明:该细胞于1988年建系;源于一名64岁患有急性粒细胞白血病(AMLM7)的男性的骨髓;对多种细胞因子有反应。;传代方法:维持细胞浓度在1.0-1.5×106cells/ml,1:2传代,2-3天1次。;生长特性:悬浮生长,有1%~2%的细胞可轻微贴壁。;形态特性:圆形;相关产品有:HCCC-9810细胞、Panc_04_03细胞、FL62891细胞
AML193 Cells;背景说明:详见相关文献介绍;传代方法:1:2传代。3天内可长满。;生长特性:悬浮生长;形态特性:淋巴母细胞;相关产品有:NCIH146细胞、MOLP2细胞、GM01232E细胞
CMT-64 Cells;背景说明:肺腺癌;雌性;C57;传代方法:1:2-1:3传代;每周换液2-3次。;生长特性:贴壁;形态特性:详见产品说明书;相关产品有:GP2d细胞、tdott细胞、UMNSAH-DF1细胞
H2347 Cells;背景说明:详见相关文献介绍;传代方法:1:2-1:6传代,每周2-3次。;生长特性:贴壁生长;形态特性:上皮样;相关产品有:ChaGo-K1细胞、P388细胞、Centre Antoine Lacassagne-148细胞
KYSE-30 Cells;背景说明:来源于一位64岁,患有高分化的中段食管鳞癌的男性患者。;传代方法:1:2-1:3传代;每周换液2-3次。;生长特性:贴壁;形态特性:上皮细胞样;相关产品有:95-D细胞、NCTC929细胞、3T3 L1细胞
HCV-29 Cells;背景说明:膀胱;男性;传代方法:1:2-1:3传代;每周换液2-3次。;生长特性:贴壁;形态特性:详见产品说明书;相关产品有:E.L.4细胞、NCI-H-295细胞、Hmy.2 CIR细胞
COLO-680N Cells;背景说明:详见相关文献介绍;传代方法:1:2-1:3传代;每周换液2-3次。;生长特性:贴壁或悬浮,详见产品说明书部分;形态特性:详见产品说明书;相关产品有:HEK-293FT细胞、KP 4细胞、HGSMC细胞
RBL-1 Cells;背景说明:详见相关文献介绍;传代方法:1:2-1:3传代;每周换液2-3次。;生长特性:贴壁或悬浮,详见产品说明书部分;形态特性:详见产品说明书;相关产品有:RBVEC细胞、Hs 604.T细胞、GM00215细胞
CAL62 Cells;背景说明:详见相关文献介绍;传代方法:1:2-1:3传代;每周换液2-3次。;生长特性:贴壁或悬浮,详见产品说明书部分;形态特性:详见产品说明书;相关产品有:H-2405细胞、NCI-H-82细胞、AgC11x3A细胞
EOC-20 Cells;背景说明:详见相关文献介绍;传代方法:1:2-1:3传代;每周换液2-3次。;生长特性:贴壁或悬浮,详见产品说明书部分;形态特性:详见产品说明书;相关产品有:SU-DHL-10细胞、KYSE-30细胞、MTC-TT细胞
BT 325 Cells;背景说明:详见相关文献介绍;传代方法:1:2-1:3传代;每周换液2-3次。;生长特性:贴壁或悬浮,详见产品说明书部分;形态特性:详见产品说明书;相关产品有:BCaP-37细胞、KNS-62细胞、DU-4475细胞
COLO-320-DM Cells;背景说明:该细胞可产生5-羟色胺、去甲、、ACTH和甲状旁腺素。角蛋白、波形蛋白弱阳性。培养条件: RPMI 1640 10%FBS;传代方法:1:2-1:3传代;每周换液2-3次。;生长特性:悬浮+贴壁;形态特性:淋巴细胞;相关产品有:GEO细胞、KYSE-520细胞、SW1353细胞
HMEC1 Cells;背景说明:详见相关文献介绍;传代方法:1:2传代;生长特性:贴壁生长;形态特性:上皮细胞样;相关产品有:LTEP-sm 1细胞、PCI-4B细胞、MDA-MB-134 VI细胞
MMAc.SF Cells;背景说明:详见相关文献介绍;传代方法:1:2传代;生长特性:贴壁生长;形态特性:详见产品说明书;相关产品有:PIEC细胞、NCIH2452细胞、CDC/EU.HMEC-1细胞
LTEP-sm 1 Cells;背景说明:小细胞肺癌;男性;传代方法:1:2-1:3传代;每周换液2-3次。;生长特性:贴壁;形态特性:详见产品说明书;相关产品有:Mono-Mac-6细胞、UPCI-SCC-090细胞、SNU-475细胞
8305C Cells;背景说明:详见相关文献介绍;传代方法:1:6传代;生长特性:贴壁或悬浮,详见产品说明书部分;形态特性:详见产品说明书;相关产品有:MKN28细胞、NCI-H719细胞、SK-MEL2细胞
PANC0203 Cells;背景说明:详见相关文献介绍;传代方法:1:2传代;生长特性:贴壁生长;形态特性:上皮样;相关产品有:SK-BR3细胞、SNU423细胞、HeLa 229细胞
K7M2 wt Cells;背景说明:骨肉瘤;肺转移;雌性;BALB/c;传代方法:1:2-1:3传代;每周换液2-3次。;生长特性:贴壁;形态特性:详见产品说明书;相关产品有:Caov-4细胞、J-774A.1细胞、Jeko1细胞
LS-174T Cells;背景说明:LS 174T是LS 180 (ATCC CL 187)结肠腺癌细胞株的胰蛋白酶化变种。 它比亲本更易传代,象LS 180一样生成大量的癌胚抗原(CEA)。 电镜研究表明有丰富的微丝和细胞质粘液素液泡。 直肠抗原3阳性。 p53抗原表达阴性,但mRNA表达阳性。 与ATCC CL-187来源于同一个肿瘤。LS 174T细胞角蛋白染色阳性。 癌基因c-myc, N-myc, H-ras, N-ras, Myb, 和 fos的表达呈阳性。 癌基因k-ras和sis的表达未做检测。;传代方法:1:2传代;生长特性:贴壁生长;形态特性:上皮样;相关产品有:H4-II-EC3细胞、NCIH1869细胞、SKCol1细胞
Fetal Human Lens-124 Cells;背景说明:晶状体上皮;自发永生;传代方法:1:2-1:3传代;每周换液2-3次。;生长特性:贴壁;形态特性:详见产品说明书;相关产品有:bEnd.3[BEND3]细胞、A375-S2细胞、A-431细胞
T-CAM2 Cells;背景说明:睾丸精原细胞瘤;男性;传代方法:1:2-1:3传代;每周换液2-3次。;生长特性:贴壁;形态特性:详见产品说明书;相关产品有:SUM-52PE细胞、Clone Y1细胞、H1993细胞
MDA-MB-361 Cells;背景说明:该细胞源自40岁女性乳腺癌的脑转移组织。;传代方法: 1:2—1:6传代,每周换液2—3次;生长特性:松散贴壁生长;形态特性:上皮细胞样;相关产品有:LICR-LON-HN6细胞、FU-MMT-1细胞、Walker256-TC细胞
SUM-159PT Cells;背景说明:乳腺癌;女性;传代方法:1:2-1:3传代;每周换液2-3次。;生长特性:贴壁;形态特性:详见产品说明书;相关产品有:Hs683细胞、OCI-LY-3细胞、LC2/Ad细胞
KALS-1 Cells;背景说明:详见相关文献介绍;传代方法:1:2传代;生长特性:贴壁生长;形态特性:多边形;相关产品有:RA 1细胞、SUDHL1细胞、OVCA433细胞
CNE2Z Cells;背景说明:鼻咽癌;传代方法:1:2-1:3传代;每周换液2-3次。;生长特性:贴壁;形态特性:详见产品说明书;相关产品有:LOU-NH-91细胞、COS-1细胞、CNE细胞
UMNSAH/DF-1 Cells鸡胚成纤维贴壁细胞系(提供所有细胞STR鉴定图谱)
MDCK.2 Cells;背景说明:详见相关文献介绍;传代方法:1:2-1:3传代;每周换液2-3次。;生长特性:贴壁或悬浮,详见产品说明书部分;形态特性:详见产品说明书;相关产品有:Michigan Cancer Foundation-10A细胞、Shadyside Hospital Pittsburgh-77细胞、Hep G2-Luc细胞
Pfeiffer Cells;背景说明:详见相关文献介绍;传代方法:1:2传代;生长特性:悬浮生长;形态特性:淋巴母细胞样;相关产品有:L-Wnt-3A细胞、OCILY7细胞、MFHL-2细胞
WiDr-TC Cells;背景说明:结肠癌;女性;传代方法:1:2-1:3传代;每周换液2-3次。;生长特性:贴壁;形态特性:详见产品说明书;相关产品有:Los Angeles Prostate Cancer-4细胞、SUM-190PT细胞、WIL2 Secreting细胞
HCC-1143 Cells;背景说明:详见相关文献介绍;传代方法:1:2—1:4传代,每周换液2—3次;生长特性:贴壁生长;形态特性:上皮样;相关产品有:University of Michigan-Urothelial Carcinoma-3细胞、VMCUB-1细胞、M-07e细胞
TF-1a Cells;背景说明:详见相关文献介绍;传代方法:1:2-1:3传代;每周换液2-3次。;生长特性:贴壁或悬浮,详见产品说明书部分;形态特性:详见产品说明书;相关产品有:Karpas299细胞、KYSE-140细胞、S37细胞
IAR 20 Cells;背景说明:肝; BDVI;传代方法:1:2-1:3传代;每周换液2-3次。;生长特性:贴壁;形态特性:详见产品说明书;相关产品有:NG-108-15细胞、N9细胞、293 F细胞
Pt K2 (NBL-5) Cells;背景说明:详见相关文献介绍;传代方法:1:2-1:3传代;每周换液2-3次。;生长特性:贴壁或悬浮,详见产品说明书部分;形态特性:详见产品说明书;相关产品有:NP69SV40T细胞、RMG1细胞、SF-767细胞
PLC/PRF5 Cells;背景说明:该细胞系分泌乙肝病毒表面抗原(HBsAg)。 此细胞系原先被支原体污染,后用BM-cycline去除支原体;传代方法:1:2传代;生长特性:贴壁生长;形态特性:上皮样;相关产品有:KYSE 510细胞、P3J HR1-K细胞、Mono Mac 6细胞
┈订┈购(技术服务)┈热┈线:1┈3┈6┈4┈1┈9┈3┈0┈7┈9┈1【微信同号】┈Q┈Q:3┈1┈8┈0┈8┈0┈7┈3┈2┈4;
NCI-H1869 Cells;背景说明:详见相关文献介绍;传代方法:1:3-1:4传代;每周换液2次。;生长特性:贴壁生长;形态特性:上皮细胞;相关产品有:LS-1034细胞、BGC-823细胞、NCIH1930细胞
Human Kidney-2 Cells;背景说明:该细胞属源于正常肾的近曲小管细胞,通过导入HPV-16 E6/E7基因而获得永生化。将含有HPV-16 E6/E7基因的重组的逆转录病毒载体pLXSN 16 E6/E7转染外生包装细胞Psi-2,Psi-2细胞产生的病毒再去感染兼嗜性包装细胞系PA317,最后将PA317产生的病毒颗粒导入正常的肾皮质近曲小管细胞。尽管pLXSN 16 E6/E7中含有新霉素抗性,但未用G418筛选转导克隆。Southern和FISH分析显示HK-2细胞来源于单克隆。PCR检测证实HK-2细胞基因组中含有E6/E7基因。;传代方法:1:4传代;2-3天换液1次;生长特性:贴壁生长;形态特性:上皮样;相关产品有:NPA-87细胞、OCI-Ly19细胞、JVM2细胞
U-343MG Cells;背景说明:详见相关文献介绍;传代方法:1:2传代;生长特性:贴壁生长 ;形态特性:详见产品说明书;相关产品有:RCK-8细胞、Walker/LLC-WRC 256细胞、2B4-L细胞
BayGenomics ES cell line CSJ102 Cells(提供STR鉴定图谱)
BayGenomics ES cell line SYA377 Cells(提供STR鉴定图谱)
CC98 Cells(提供STR鉴定图谱)
M0545YM029S2 Cells(提供STR鉴定图谱)
RdMab-2 Cells(提供STR鉴定图谱)
RTC3 Cells(提供STR鉴定图谱)
"